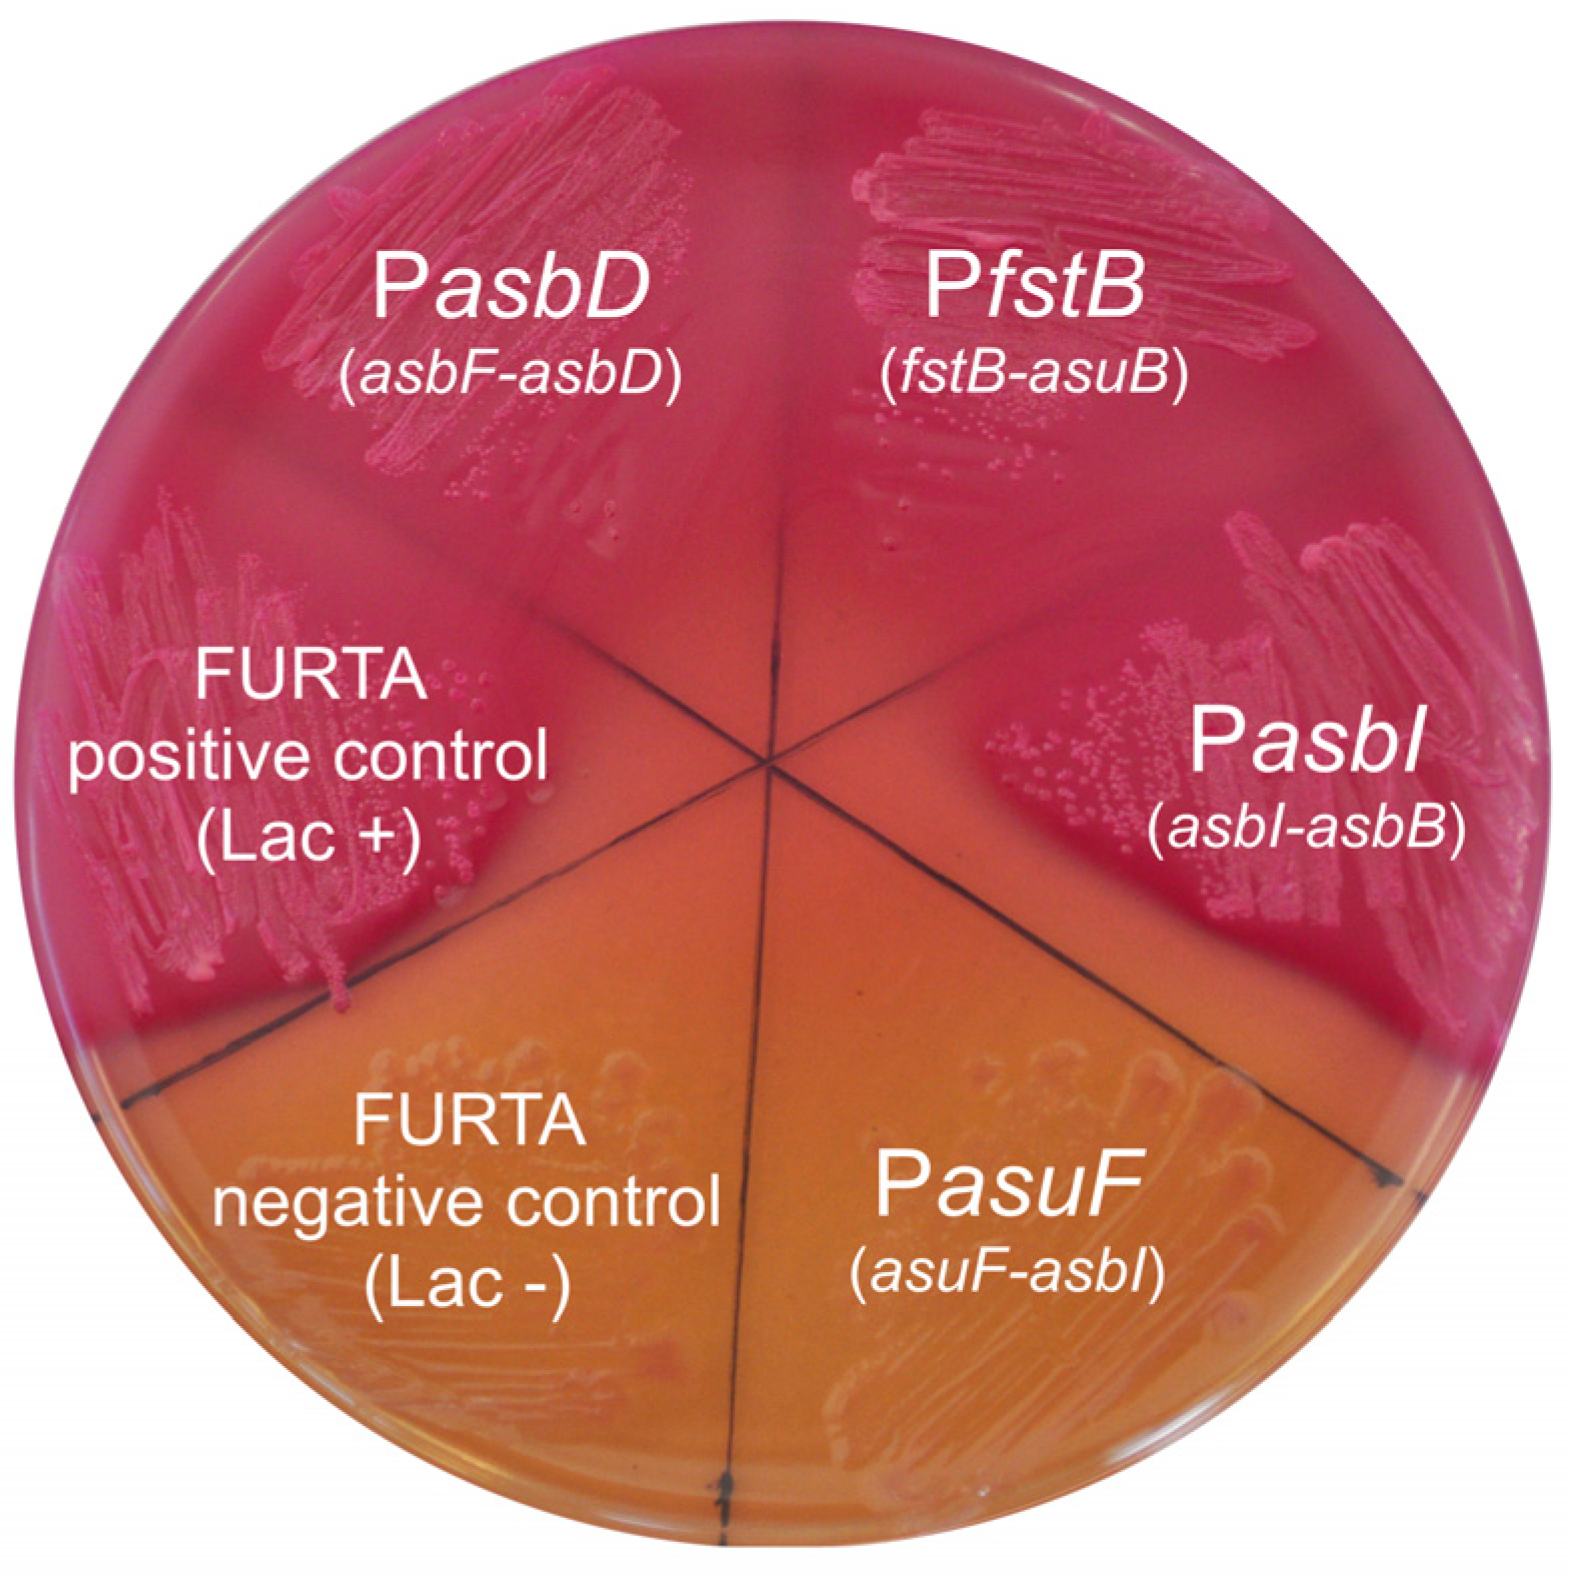

The Sigma Factor AsbI Is Required for the Expression of Acinetobactin Siderophore Transport Genes in Aeromonas salmonicida
Abstract
1. Introduction
2. Results
2.1. Inactivation of asbI Reduces the Ability to Grow under Iron-Restricted Conditions
2.2. AsbI Regulates the Expression of Acinetobactin Transport Functions, but Not Its Synthesis
2.3. Presence of Fur-Boxes in Acinetobactin Promoters
2.4. In Silico Prediction of AsbI Interactions with Other Proteins
3. Discussion
4. Materials and Methods
4.1. Bacterial Strains, Plasmids and Culture Media
4.2. Mutant Construction and Complementation of asbI Gene
4.3. DNA Manipulation
4.4. Growth under Iron-Limiting Conditions
4.5. Quantification of Siderophores (CAS Assay)
4.6. Promoter Fusions
4.7. Fur Titration Assay (FURTA)
4.8. Bioinformatic Tools
Author Contributions
Funding
Institutional Review Board Statement
Informed Consent Statement
Data Availability Statement
Conflicts of Interest
References
- Begg, S.L. The role of metal ions in the virulence and viability of bacterial pathogens. Biochem. Soc. Trans. 2019, 47, 77–87. [Google Scholar] [CrossRef]
- Kramer, J.; Özkaya, Ö.; Kümmerli, R. Bacterial siderophores in community and host interactions. Nat. Rev. Microbiol. 2020, 18, 152–163. [Google Scholar] [CrossRef] [PubMed]
- Lemos, M.L.; Balado, M. Iron uptake mechanisms as key virulence factors in bacterial fish pathogens. J. Appl. Microbiol. 2020, 129, 104–115. [Google Scholar] [CrossRef] [PubMed]
- Toranzo, A.E.; Magariños, B.; Romalde, J.L. A review of the main bacterial fish diseases in mariculture systems. Aquaculture 2005, 246, 37–61. [Google Scholar] [CrossRef]
- Najimi, M.; Lemos, M.L.; Osorio, C.R. Identification of siderophore biosynthesis genes essential for growth of Aeromonas salmonicida under iron limitation conditions. Appl. Environ. Microbiol. 2008, 74, 2341–2348. [Google Scholar] [CrossRef]
- Lemos, M.L.; Osorio, C.R. Iron Uptake in Vibrio and Aeromonas. In Iron Uptake and Homeostasis in Microorganisms; Cornelis, P., Andrews, S.C., Eds.; Caister Academic Press: Norfolk, UK, 2010; pp. 117–141. ISBN 9781904455653. [Google Scholar]
- Balado, M.; Souto, A.; Vences, A.; Careaga, V.P.; Valderrama, K.; Segade, Y.; Rodríguez, J.; Osorio, C.R.; Jiménez, C.; Lemos, M.L. Two catechol siderophores, acinetobactin and amonabactin, are simultaneously produced by Aeromonas salmonicida subsp. salmonicida sharing part of the biosynthetic pathway. ACS Chem. Biol. 2015, 10, 2850–2860. [Google Scholar] [CrossRef]
- Esmaeel, Q.; Chevalier, M.; Chataigné, G.; Subashkumar, R.; Jacques, P.; Leclère, V. Nonribosomal peptide synthetase with a unique iterative-alternative-optional mechanism catalyzes amonabactin synthesis in Aeromonas. Appl. Microbiol. Biotechnol. 2016, 100, 8453–8463. [Google Scholar] [CrossRef] [PubMed]
- Yamamoto, S.; Okujo, N.; Sakakibara, Y. Isolation and structure elucidation of acinetobactin, a novel siderophore from Acinetobacter baumannii. Arch Microbiol 1994, 162, 249–254. [Google Scholar] [CrossRef]
- Telford, J.R.; Leary, J.A.; Tunstad, L.M.G.; Byers, B.R.; Raymond, K.N. Amonabactin: Characterization of a series of siderophores from Aeromonas hydrophila. J. Am. Chem. Soc. 1994, 116, 4499–4500. [Google Scholar] [CrossRef]
- Balado, M.; Segade, Y.; Rey, D.; Osorio, C.R.; Rodríguez, J.; Lemos, M.L.; Jiménez, C. Identification of the ferric-acinetobactin outer membrane receptor in Aeromonas salmonicida subsp. salmonicida and structure–Activity relationships of synthetic acinetobactin analogues. ACS Chem. Biol. 2017, 12, 479–493. [Google Scholar] [CrossRef] [PubMed]
- Rey-Varela, D.; Cisneros-Sureda, J.; Balado, M.; Rodríguez, J.; Lemos, M.L.; Jiménez, C. The outer membrane protein FstC of Aeromonas salmonicida subsp. salmonicida acts as receptor for amonabactin siderophores and displays a wide ligand plasticity. Structure–activity relationships of synthetic amonabactin analogues. ACS Infect. Dis. 2019, 5, 1936–1951. [Google Scholar] [CrossRef] [PubMed]
- Matthijs, S.; Laus, G.; Meyer, J.-M.M.; Abbaspour-Tehrani, K.; Schäfer, M.; Budzikiewicz, H.; Cornelis, P.; Schafer, M.; Budzikiewicz, H.; Cornelis, P. Siderophore-mediated iron acquisition in the entomopathogenic bacterium Pseudomonas entomophila L48 and its close relative Pseudomonas putida KT2440. Biometals 2009, 21, 21. [Google Scholar] [CrossRef] [PubMed]
- Mihara, K.; Tanabe, T.; Yamakawa, Y.; Funahashi, T.; Nakao, H.; Narimatsu, S.; Yamamoto, S. Identification and transcriptional organization of a gene cluster involved in biosynthesis and transport of acinetobactin, a siderophore produced by Acinetobacter baumannii ATCC 19606T. Microbiology 2004, 150, 2587–2597. [Google Scholar] [CrossRef]
- Andrews, S.C.; Robinson, A.K.; Rodriguez-Quinones, F. Bacterial iron homeostasis. FEMS Microbiol. Rev. 2003, 27, 215–237. [Google Scholar] [CrossRef] [PubMed]
- Troxell, B.; Hassan, H.M. Transcriptional regulation by Ferric Uptake Regulator (Fur) in pathogenic bacteria. Front. Cell. Infect. Microbiol. 2013, 3, 59. [Google Scholar] [CrossRef] [PubMed]
- Sheldon, J.R.; Heinrichs, D.E. Recent developments in understanding the iron acquisition strategies of gram positive pathogens. FEMS Microbiol. Rev. 2015, 39, 592–630. [Google Scholar] [CrossRef]
- Otero-Asman, J.R.; Wettstadt, S.; Bernal, P.; Llamas, M.A. Diversity of extracytoplasmic function sigma (σECF) factor-dependent signaling in Pseudomonas. Mol. Microbiol. 2019, 112, 356–373. [Google Scholar] [CrossRef]
- Ishihama, A. Functional modulation of Escherichia coli RNA polymerase. Annu. Rev. Microbiol. 2000, 54, 499–518. [Google Scholar] [CrossRef]
- Finn, R.D.; Bateman, A.; Clements, J.; Coggill, P.; Eberhardt, R.Y.; Eddy, S.R.; Heger, A.; Hetherington, K.; Holm, L.; Mistry, J.; et al. Pfam: The protein families database. Nucleic Acids Res. 2014, 42, D222–D230. [Google Scholar] [CrossRef]
- Martínez-García, E.; Goñi-Moreno, A.; Bartley, B.; McLaughlin, J.; Sánchez-Sampedro, L.; Pascual Del Pozo, H.; Prieto Hernández, C.; Marletta, A.S.; De Lucrezia, D.; Sánchez-Fernández, G.; et al. SEVA 3.0: An update of the Standard European Vector Architecture for enabling portability of genetic constructs among diverse bacterial hosts. Nucleic Acids Res. 2020, 48, D1164–D1170. [Google Scholar] [CrossRef]
- Savioz, A.; Jeenes, D.J.; Kocher, H.P.; Haas, D. Comparison of proC and other housekeeping genes of Pseudomonas aeruginosa with their counterparts in Escherichia coli. Gene 1990, 86, 107–111. [Google Scholar] [CrossRef]
- Rivera, L.; López-Patiño, M.A.; Milton, D.L.; Nieto, T.P.; Farto, R. Effective qPCR methodology to quantify the expression of virulence genes in Aeromonas salmonicida subsp. salmonicida. J. Appl. Microbiol. 2015, 118, 792–802. [Google Scholar] [CrossRef]
- Beare, P.A.; For, R.J.; Martin, L.W.; Lamont, I.L. Siderophore-mediated cell signalling in Pseudomonas aeruginosa: Divergent pathways regulate virulence factor production and siderophore receptor synthesis. Mol. Microbiol. 2003, 47, 195–207. [Google Scholar] [CrossRef]
- Balado, M.; Osorio, C.R.; Lemos, M.L. Biosynthetic and regulatory elements involved in the production of the siderophore vanchrobactin in Vibrio anguillarum. Microbiology 2008, 154, 1400–1413. [Google Scholar] [CrossRef]
- Paget, M.S. Bacterial sigma factors and anti-sigma factors: Structure, function and distribution. Biomolecules 2015, 5, 1245–1265. [Google Scholar] [CrossRef] [PubMed]
- Lonetto, M.A.; Brown, K.L.; Rudd, K.E.; Buttner, M.J. Analysis of the Streptomyces coelicolor sigE gene reveals the existence of a subfamily of eubacterial RNA polymerase sigma factors involved in the regulation of extracytoplasmic functions. Proc. Natl. Acad. Sci. USA 1994, 91, 7573–7577. [Google Scholar] [CrossRef] [PubMed]
- Braun, V. Surface signaling: Novel transcription initiation mechanism starting from the cell surface. Arch. Microbiol. 1997, 167, 325–331. [Google Scholar] [CrossRef] [PubMed]
- Cunliffe, H.E.; Merriman, T.R.; Lamont, I.L. Cloning and characterization of pvdS, a gene required for pyoverdine synthesis in Pseudomonas aeruginosa: PvdS is probably an alternative sigma factor. J. Bacteriol. 1995, 177, 2744–2750. [Google Scholar] [CrossRef] [PubMed]
- Vanderpool, C.K.; Armstrong, S.K. The Bordetella bhu locus is required for heme iron utilization. J. Bacteriol. 2001, 183, 4278–4287. [Google Scholar] [CrossRef]
- Pradel, E.; Locht, C. Expression of the putative siderophore receptor gene bfrZ is controlled by the extracytoplasmic-function sigma factor BupI in Bordetella bronchiseptica. J. Bacteriol. 2001, 183, 2910–2917. [Google Scholar] [CrossRef] [PubMed]
- Burgos, J.M.; King-Lyons, N.D.; Connell, T.D. Expression of BfrH, a putative siderophore receptor of Bordetella bronchiseptica, is regulated by iron, fur1, and the extracellular function sigma factor EcfI. Infect. Immun. 2010, 78, 1147–1162. [Google Scholar] [CrossRef]
- Rédly, G.A.; Poole, K. Pyoverdine-mediated regulation of FpvA synthesis in Pseudomonas aeruginosa: Involvement of a probable extracytoplasmic-function sigma factor, FpvI. J. Bacteriol. 2003, 185, 1261–1265. [Google Scholar] [CrossRef]
- Staroń, A.; Sofia, H.J.; Dietrich, S.; Ulrich, L.E.; Liesegang, H.; Mascher, T. The third pillar of bacterial signal transduction: Classification of the extracytoplasmic function (ECF) sigma factor protein family. Mol. Microbiol. 2009, 74, 557–581. [Google Scholar] [CrossRef]
- Agnoli, K.; Lowe, C.A.; Farmer, K.L.; Husnain, S.I.; Thomas, M.S. The ornibactin biosynthesis and transport genes of Burkholderia cenocepacia are regulated by an extracytoplasmic function sigma factor which is a part of the Fur regulon. J. Bacteriol. 2006, 188, 3631–3644. [Google Scholar] [CrossRef]
- Alice, A.F.; Lopez, C.S.; Lowe, C.A.; Ledesma, M.A.; Crosa, J.H. Genetic and transcriptional analysis of the siderophore malleobactin biosynthesis and transport genes in the human pathogen Burkholderia pseudomallei K96243. J. Bacteriol. 2006, 188, 1551–1566. [Google Scholar] [CrossRef] [PubMed]
- Braun, V.; Endriss, F. Energy-coupled outer membrane transport proteins and regulatory proteins. Biometals 2007, 20, 219–231. [Google Scholar] [CrossRef] [PubMed]
- Koster, M.; Van Klompenburg, W.; Bitter, W.; Leong, J.; Weisbeek, P. Role for the outer membrane ferric siderophore receptor PupB in signal transduction across the bacterial cell envelope. EMBO J. 1994, 13, 2805–2813. [Google Scholar] [CrossRef] [PubMed]
- Vanderpool, C.K.; Armstrong, S.K. Heme-responsive transcriptional activation of Bordetella bhu genes. J. Bacteriol. 2003, 185, 909–917. [Google Scholar] [CrossRef]
- Grove, A. Extracytoplasmic function sigma factors governing production of the primary siderophores in pathogenic Burkholderia species. Front. Microbiol. 2022, 13, 514. [Google Scholar] [CrossRef]
- Lages, M.A.; Lemos, M.L.; Balado, M. The temperature-dependent expression of the High-Pathogenicity Island encoding piscibactin in Vibrionaceae results from the combined effect of the AraC-like transcriptional activator PbtA and regulatory factors from the recipient genome. Front. Microbiol. 2021, 12, 3448. [Google Scholar] [CrossRef]
- Maunsell, B.; Adams, C.; O’Gara, F. Complex regulation of AprA metalloprotease in Pseudomonas fluorescens M114: Evidence for the involvement of iron, the ECF sigma factor, PbrA and pseudobactin M114 siderophore. Microbiology 2006, 152, 29–42. [Google Scholar] [CrossRef]
- Miller, J.H. Experiments in Molecular Genetics; Cold Spring Harbor Laboratory: Laurel Hollow, NY, USA, 1972; ISBN 0879691069. [Google Scholar]
- Hantke, K. Selection procedure for deregulated iron transport mutants (fur) in Escherichia coli K 12: Fur not only affects iron metabolism. Mol. Gen. Genet. 1987, 210, 135–139. [Google Scholar] [CrossRef]
- Tabor, S.; Richardson, C.C. A bacteriophage T7 RNA polymerase/promoter system for controlled exclusive expression of specific genes. Biotechnology 1992, 24, 280–284. [Google Scholar] [CrossRef]
- Mourino, S.; Osorio, C.R.; Lemos, M.L. Characterization of heme uptake cluster genes in the fish pathogen Vibrio anguillarum. J. Bacteriol. 2004, 186, 6159–6167. [Google Scholar] [CrossRef]
- Correa, N.E.; Lauriano, C.M.; McGee, R.; Klose, K.E. Phosphorylation of the flagellar regulatory protein FlrC is necessary for Vibrio cholerae motility and enhanced colonization. Mol. Microbiol. 2000, 35, 743–755. [Google Scholar] [CrossRef]
- Wang, R.F.; Kushner, S.R. Construction of versatile low-copy-number vectors for cloning, sequencing and gene expression in Escherichia coli. Gene 1991, 100, 195–199. [Google Scholar] [CrossRef] [PubMed]
- Herrero, M.; de Lorenzo, V.; Timmis, K.N. Transposon vectors containing non-antibiotic resistance selection markers for cloning and stable chromosomal insertion of foreign genes in gram-negative bacteria. J. Bacteriol. 1990, 172, 6557–6567. [Google Scholar] [CrossRef] [PubMed]
- Lemos, M.L.; Salinas, P.; Toranzo, A.E.; Barja, J.L.; Crosa, J.H. Chromosome-mediated iron uptake system in pathogenic strains of Vibrio anguillarum. J. Bacteriol. 1988, 170, 1920–1925. [Google Scholar] [CrossRef]
- Schwyn, B.; Neilands, J.B. Universal chemical assay for the detection and determination of siderophores. Anal. Biochem. 1987, 160, 47–56. [Google Scholar] [CrossRef] [PubMed]
- Souto, A.; Montaos, M.A.; Rivas, A.J.; Balado, M.; Osorio, C.R.; Rodríguez, J.; Lemos, M.L.; Jiménez, C. Structure and biosynthetic assembly of piscibactin, a siderophore from Photobacterium damselae subsp. piscicida, predicted from genome analysis. Eur. J. Org. Chem. 2012, 2012, 5693–5700. [Google Scholar] [CrossRef]
- Stojiljkovic, I.; Bäumler, A.J.; Hantke, K. Fur regulon in gram-negative bacteria. Identification and characterization of new iron-regulated Escherichia coli genes by a fur titration assay. J. Mol. Biol. 1994, 236, 531–545. [Google Scholar] [CrossRef] [PubMed]
- Osorio, C.R.; Lemos, M.L.; Braun, V. Identification of Fur regulated genes in the bacterial fish pathogen Photobacterium damselae ssp. piscicida using the Fur titration assay. Biometals 2004, 17, 725–733. [Google Scholar] [CrossRef] [PubMed]

| Strain/Plasmids | Description | Reference |
|---|---|---|
| Aeromonas salmonicida subsp. salmonicida | ||
| RSP74.1 | Isolated from turbot, Portugal, Cmr | [5] |
| RSP74.1 ΔasbD | RSP74.1 defective in the acinetobactin synthesis gene asbD, Cmr | [5] |
| RSP74.1 ΔfstB | RSP74.1 defective in the acinetobactin transporter gene fstB, Cmr | [11] |
| RSP74.1 ΔasbI | RSP74.1 defective in the acinetobactin putative regulator gene asbI, Cmr | This study |
| Escherichia coli | ||
| DH5α | Cloning strain | Laboratory stock |
| H1717 | Strain used in FURTA assay araD139 ΔlacU169 rpsL150 relA1 flbB5301 deoC1 ptsF25 rbsR aroB fhuF::λ placMu | [44] |
| Plasmids | ||
| pT7-7 | Cloning vector, Apr | [45] |
| pNidKan | Plasmid with sucrose selection, Kanr | [46] |
| pDR216 | pSEVA651 containing wild-type asbI | This study |
| Oligonucleotide | Sequence (5′ -> 3′) | Size (bp) |
|---|---|---|
| asbI_del_1_XbaI | CCGTCTAGATAAACGCCTTGAAGGCATCG | 1018 |
| asbI_del_2_BamHI | GGCGGATCCCTCAATGGTATGGGCTACCA | |
| asbI_del_3_BamHI | CCCGGATCCCCGATATAACGTCTGCCACT | 905 |
| asbI_del_4_XhoI | GCGCTCGAGTAAGCGTCATTTCAGGGCTG | |
| asbHJ_compl-1_XbaI | GCGTCTAGATTCCAGAGAAGGCAGATGCG | 5132 |
| asbJ_compl-2_BamHI | GCGGGATCCATCTGCTGCAATATGACCCC |
| Oligonucleotide | Sequence (5′ -> 3′) | Size (bp) |
|---|---|---|
| Promoter fusion of fstB | ||
| fstB_fusP-F-V2_KpnI | GCGGGTACCGCACAAACTCAAGCCGGATC | 822 |
| fstB_fusP-R-V2_XbaI | CCGTCTAGAAGGATGCAACAGATGGGGCT | |
| Promoter fusion of asuF | ||
| asuF_fusP-F-V2_BamHI | GCGGGATCCGAGAGGGAAGCTTGCTCCTT | 700 |
| asuF_fusP-R-V2_XbaI | GCGTCTAGACGCGGCTTTGGAATCAAGAA | |
| Promoter fusion of asbI | ||
| asbI_fusP-F-V2_BamHI | GCGGGATCCGGCACTCAATACCATGACGA | 976 |
| asbI_fusP-R-V2_XbaI | GCGTCTAGACTGTTCCTGCAAGGAGCAAG | |
| Promoter fusion of asbD | ||
| asbD_fusPromot-1_BamHI | GCGGGATCCGCAGCAAATCGCATCACTCG | 563 |
| asbD_fusPromot-2_XbaI | GCGTCTAGAAACCTCACCCAGTGCTGAGT | |
| Promoter fusion of asbB | ||
| asbB_fusP-F_BamHI | GCGGGATCCTGAGTGCAGGTTGCTGGGTT | 551 |
| asbB_fusPromot-2_XbaI | GCGTCTAGATTCATGAGTGCTCACAGGTA | |
| Promoter fusion of asbG | ||
| asbG_fusP-F-V2_BamHI | GCGGGATCCAATGATTAGCCATCAATGGC | 452 |
| asbG_fusP-R-V2_XbaI | GCGTCTAGACCCGGCATCTTCTGATGACA | |
| Promoter fusion of asbF | ||
| asbF_fusP-F_BamHI | GCGGGATCCTTTCAGCCACTGTCTGCATG | 592 |
| asbF_fusP-R-V2_XbaI | CCGTCTAGAAAGTTGCTGTACGCGCTCTT | |
| Promoter fusion of proC | ||
| proC_fusP-R-V2_XbaI | GCGTCTAGAGATACTGCGGCTCATATTGC | 800 |
| proC_fusP-F-V2_BamHI | GCGGGATCCAGGAACGTATTGTACAGGCC |
Disclaimer/Publisher’s Note: The statements, opinions and data contained in all publications are solely those of the individual author(s) and contributor(s) and not of MDPI and/or the editor(s). MDPI and/or the editor(s) disclaim responsibility for any injury to people or property resulting from any ideas, methods, instructions or products referred to in the content. |
© 2023 by the authors. Licensee MDPI, Basel, Switzerland. This article is an open access article distributed under the terms and conditions of the Creative Commons Attribution (CC BY) license (https://creativecommons.org/licenses/by/4.0/).
Share and Cite
Rey-Varela, D.; Balado, M.; Lemos, M.L. The Sigma Factor AsbI Is Required for the Expression of Acinetobactin Siderophore Transport Genes in Aeromonas salmonicida. Int. J. Mol. Sci. 2023, 24, 9672. https://doi.org/10.3390/ijms24119672
Rey-Varela D, Balado M, Lemos ML. The Sigma Factor AsbI Is Required for the Expression of Acinetobactin Siderophore Transport Genes in Aeromonas salmonicida. International Journal of Molecular Sciences. 2023; 24(11):9672. https://doi.org/10.3390/ijms24119672
Chicago/Turabian StyleRey-Varela, Diego, Miguel Balado, and Manuel L. Lemos. 2023. "The Sigma Factor AsbI Is Required for the Expression of Acinetobactin Siderophore Transport Genes in Aeromonas salmonicida" International Journal of Molecular Sciences 24, no. 11: 9672. https://doi.org/10.3390/ijms24119672
APA StyleRey-Varela, D., Balado, M., & Lemos, M. L. (2023). The Sigma Factor AsbI Is Required for the Expression of Acinetobactin Siderophore Transport Genes in Aeromonas salmonicida. International Journal of Molecular Sciences, 24(11), 9672. https://doi.org/10.3390/ijms24119672

